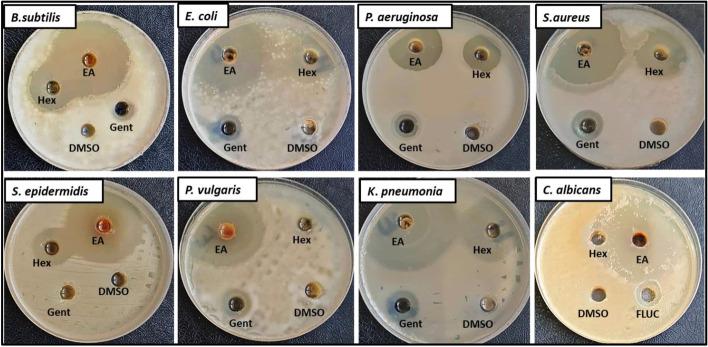
https://cdn.ncbi.nlm.nih.gov/pmc/blobs/e749/9424163/4862c1f650fd/12010_2022_3959_Fig3_HTML.jpg

来自酸枣叶的有前景的内生拟盘多毛孢:植物化学成分分析、抗菌和抗氧化活性。
Promising Endophytic Alternaria alternata from Leaves of Ziziphus spina-christi: Phytochemical Analyses, Antimicrobial and Antioxidant Activities.
机构信息
Botany and Microbiology Department, Faculty of Science, Benha University, Benha, Egypt.
The regional Center for Mycology and Biotechnology, Al-Azhar University, Cairo, 11787, Egypt.
出版信息
Appl Biochem Biotechnol. 2022 Sep;194(9):3984-4001. doi: 10.1007/s12010-022-03959-9. Epub 2022 May 17.
Fungal endophytes are considered one of the most important reservoirs of bioactive compounds which defeat resistant microbes. In our study, endophytic Alternaria alternata was isolated from Ziziphus spina-christi and identified morphologically and genetically with accession number OM 331,682. Preliminary phytochemical screening of ethyl acetate (EA) crude extract of A. alternata revealed that this extract contains alkaloids, tannins, flavonoids, glycosides, phenols, and terpenoids. Moreover, the extract was analyzed using gas chromatography-mass spectrometry (GC-MS) which verified the presence of numerous bioactive compounds. Antimicrobial results illustrated that EA crude extract exhibited promising antimicrobial activity against Gram-negative bacteria (Escherichia coli ATCC 11229, Proteus vulgaris RCMB 004, Pseudomonas aeruginosa ATCC 27853, and Klebsiella pneumonia RCMB 003), Gram-positive bacteria (Bacillus subtilis RCMB 015, Staphylococcus aureus ATCC 25923, and Staphylococcus epidermidis ATCC 14990), and unicellular fungi (Candida albicans ATCC 90028). Ultrastructure study of treated K. pneumonia showed remarkably elucidated destruction of the cell wall and cell membrane and leakage of cytoplasmic materials. Furthermore, the extract has potential antioxidant activity where IC was 409 µg/mL. Moreover, this extract did not show any toxicity on Vero normal cell line. These findings confirmed that the endophytic A. alternata from Z. spina-christi is a promising source of bioactive compounds which can be used in different biological applications.
真菌内生菌被认为是生物活性化合物的最重要储库之一,这些化合物可以战胜耐药微生物。在我们的研究中,从 Ziziphus spina-christi 中分离出内生拟盘多毛孢,并通过 OM 331,682 号登录号进行形态学和遗传学鉴定。内生拟盘多毛孢的乙酸乙酯(EA)粗提物的初步植物化学筛选表明,该提取物含有生物碱、单宁、类黄酮、糖苷、酚类和萜类化合物。此外,还使用气相色谱-质谱联用仪(GC-MS)对提取物进行了分析,证实了存在许多生物活性化合物。抗菌结果表明,EA 粗提物对革兰氏阴性菌(大肠杆菌 ATCC 11229、普通变形杆菌 RCMB 004、铜绿假单胞菌 ATCC 27853 和肺炎克雷伯菌 RCMB 003)、革兰氏阳性菌(枯草芽孢杆菌 RCMB 015、金黄色葡萄球菌 ATCC 25923 和表皮葡萄球菌 ATCC 14990)和单细胞真菌(白色念珠菌 ATCC 90028)表现出有希望的抗菌活性。处理过的肺炎克雷伯氏菌的超微结构研究表明,细胞壁和细胞膜明显被破坏,细胞质物质泄漏。此外,该提取物具有潜在的抗氧化活性,IC 为 409 µg/mL。此外,该提取物对 Vero 正常细胞系没有任何毒性。这些发现证实,来自 Z. spina-christi 的内生拟盘多毛孢是生物活性化合物的有前途的来源,可用于不同的生物应用。